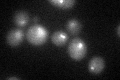

View description
Essential kinetochore protein, component of the CBF3 multisubunit complex that binds to the CDEIII region of the centromere; Cbf2p also binds to the CDEII region possibly forming a different multimeric complex, ubiquitinated in vivo
Localization:
Intensity:
Fold change:
Significance:
-
C’ GFP library in SD

punctate24.34 -
N' NOP1pr-GFP in SD

punctate,nucleus40.3225 -
N' TEF2pr-mCherry in SD

missing0 -
N' NATIVEpr-GFP in SD

missing0 -
N' TEF2pr-VC and Cyto-VN in SD

#N/A0 -
C’ GFP library in SD+DTT
punctate21.420.87No -
C’ GFP library in SD+H2O2

punctate24.451No -
C’ GFP library in Starvation Media

punctate18.850.77Yes -
C’ GFP library on the background of Pup2-DaMP

punctate -
C’ GFP library on the background of CCT mutant

punctate26.63981.09431No
